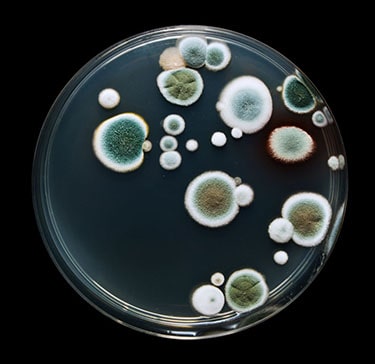
moisissures

Il est bien connu que des conditions de travail néfastes peuvent porter atteinte à la santé des travailleuses et des travailleurs. Pensons aux produits chimiques nocifs, au bruit, aux mouvements répétitifs, aux cadences élevées et aux postures contraignantes, pour ne nommer que ceux-là.
Mais qu’en est-il de l’état du bâtiment dans lequel on travaille? Nous savons, par exemple, que l’amiante contenu dans des matériaux de construction pose un immense problème lorsque ces matériaux sont en mauvais état et risquent de dégager des poussières et des fibres d’amiante. Des contrôles très rigoureux sont donc exigés par les règlements en vigueur au Québec pour tout travail avec des matériaux contenant de l’amiante.
Un autre problème en lien avec des bâtiments qui sont peu ou pas entretenus est la croissance des moisissures. Les moisissures sont en réalité des colonies visibles de champignons microscopiques. Par exemple, sur la surface d’une orange « pourrie », on voit des moisissures blanchâtres ou verdâtres. Sur les surfaces intérieures des bâtiments, ces colonies sont souvent noirâtres. Lorsqu’il y a une forte croissance de moisissures à l’intérieur d’un bâtiment, elles peuvent dégager une odeur caractéristique de terre.
Un autre problème en lien avec des bâtiments qui sont peu ou pas entretenus est la croissance des moisissures. Les moisissures sont en réalité des colonies visibles de champignons microscopiques. Par exemple, sur la surface d’une orange « pourrie », on voit des moisissures blanchâtres ou verdâtres. Sur les surfaces intérieures des bâtiments, ces colonies sont souvent noirâtres. Lorsqu’il y a une forte croissance de moisissures à l’intérieur d’un bâtiment, elles peuvent dégager une odeur caractéristique de terre.
Un bâtiment qui manque d’entretien peut être sujet à des infiltrations d’eau chroniques ou encore à des dégâts d’eau en raison d’une tuyauterie vétuste. Dans de telles situations, les matériaux de construction demeurent humides, ce qui favorise le développement et la prolifération de moisissures. L’air intérieur trop humide peut également favoriser la croissance de moisissures et d’autres agents biologiques nocifs, tels des acariens (des araignées invisibles à l’œil nu), qui sont une cause reconnue d’asthme. Enfin, un système de ventilation mal conçu ou mal entretenu peut aussi être contaminé par des moisissures. Ceci est particulièrement préoccupant, car un système ainsi contaminé distribuera les moisissures partout dans le bâtiment, affectant la qualité de l'air de l'ensemble de l'édifice.
En plus d’être désagréables à voir, les moisissures ont des effets qui peuvent être très nuisibles sur la santé. Les principaux impacts d’une exposition aux moisissures dans l’air intérieur sont des symptômes d’irritation et des effets sur le système respiratoire : irritation des yeux, du nez et de la gorge, écoulement nasal, congestion des sinus, symptômes s’apparentant à ceux du rhume, respiration sifflante, toux, augmentation de la fréquence et de la gravité des crises d’asthme, fatigue chronique et maux de tête1.
Le Dr Louis Jacques et le Dr Stéphane Perron mentionnent que l’exposition aux moisissures peut augmenter le risque de contracter des infections bactériennes et virales courantes. Ils ajoutent qu’une telle exposition peut également engendrer d’autres affections graves, mais plus rares, qui peuvent laisser des séquelles, comme un syndrome toxique2.
On le constate, l’exposition aux moisissures a de nombreux effets néfastes sur la santé et il faut s’en préoccuper. Il existe des façons d’éviter une telle exposition. L’approche la plus efficace est celle de l’entretien préventif du bâtiment. Une inspection périodique de l’enveloppe et de l’intérieur du bâtiment permettra de déceler toute anomalie devant être réparée pour éviter des infiltrations d’eau.
Si jamais un dégât d’eau se produit, une réparation rapide, dans un délai de deux jours et idéalement dans les 24 heures, empêchera la croissance de moisissures. Dans ce cas, il faut enlever tout le matériel poreux (matériel qui absorbe l’eau, comme le placoplâtre) abîmé par l’eau, incluant les structures derrière la surface abimée, car il est fort possible que celles-ci le soient aussi. Il faut également assécher rapidement les autres structures (comme le bois) encore saines. Une fois ces procédures terminées, on peut procéder aux réparations et remplacer les structures enlevées.
Enfin, tel que le prévoit l’article 104 du Règlement sur la santé et la sécurité du travail, « tout système de ventilation mécanique doit être inspecté et réglé au moins une fois par année, et les filtres entretenus ou remplacés au besoin ». En procédant ainsi, on devrait être en mesure d’éviter une contamination du système par des moisissures.
Lorsque les moyens de prévention ont fait défaut et qu’une contamination par des moisissures a été identifiée à l’intérieur d’un bâtiment, il existe des protocoles rigoureux qui décrivent la marche à suivre pour éliminer de façon complète les matériaux contaminés, tout en protégeant la santé des travailleuses et des travailleurs responsables de la décontamination ainsi que celle des occupants du bâtiment.
Il est important de mentionner que dans certains bâtiments, il y a des populations autres que les travailleuses et les travailleurs qui peuvent être encore plus vulnérables aux effets des moisissures sur la santé. Pensons aux enfants dans les écoles et les garderies ou aux personnes âgées dans les CHSLD. En protégeant les travailleuses et les travailleurs, on protège également ces populations vulnérables.
Les problèmes de santé causés par une exposition aux moisissures peuvent être reconnus comme maladie professionnelle. Par exemple, dans un dossier traité par le tribunal, impliquant plusieurs travailleurs exposés aux moisissures, le médecin de l’employeur, le comité des maladies professionnelles pulmonaires et le comité spécial des présidents ont tous affirmé que l’exposition aux moisissures n’était pas assez importante pour occasionner des problèmes, et ce, même s’il n’existe aucune norme d’exposition aux moisissures dans l’air. Le commissaire a rejeté ces arguments, reconnaissant que les problèmes respiratoires dont souffraient les travailleurs étaient associés à l’exposition aux moisissures3.
En conclusion, un bâtiment en mauvais état peut porter atteinte à la santé des travailleuses et des travailleurs, ainsi qu’à celle d’autres occupants du bâtiment. La présence d’une croissance de moisissures à l’intérieur d’un bâtiment est inacceptable en raison des effets sur la santé engendrés par une exposition à celles-ci. Il existe des moyens de prévention simples pour empêcher une telle situation de se produire et, au pire, lorsqu’un problème survient, il existe une marche à suivre très claire pour corriger la situation tout en protégeant tout le monde.
_______________
1 Centre de collaboration nationale en santé environnementale, Les Moisissures, dernière mise à jour, mars 2016.
2 Jacques L, Perron S, Et si c’était le logement, Le Médecin du Québec 2010; 45 (12) : 37-41.
3 Rousseau et Demathieu & Bard Cegerco, s.e.n.c. CLP, 9 mars 2009.
_______________
Norman King est détenteur d’une Maîtrise ès sciences en Épidémiologie.